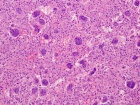
Zoom image: Cell stain

Case 6
K.M. - 42 year old male c/o a sharp, moderate, constant pain in his lower back radiating down his LLE for four months. He reports some LLE weakness, which does not limit his ambulation. He has also noticed a bulge around his left pelvis. No F/C.
Upcoming Events
Import medical school events to your Exchange, Gmail, iPhone or iPod calendar. Customize your calendar by selecting different event categories and receive automatic reminders of the school events that matter most to you.